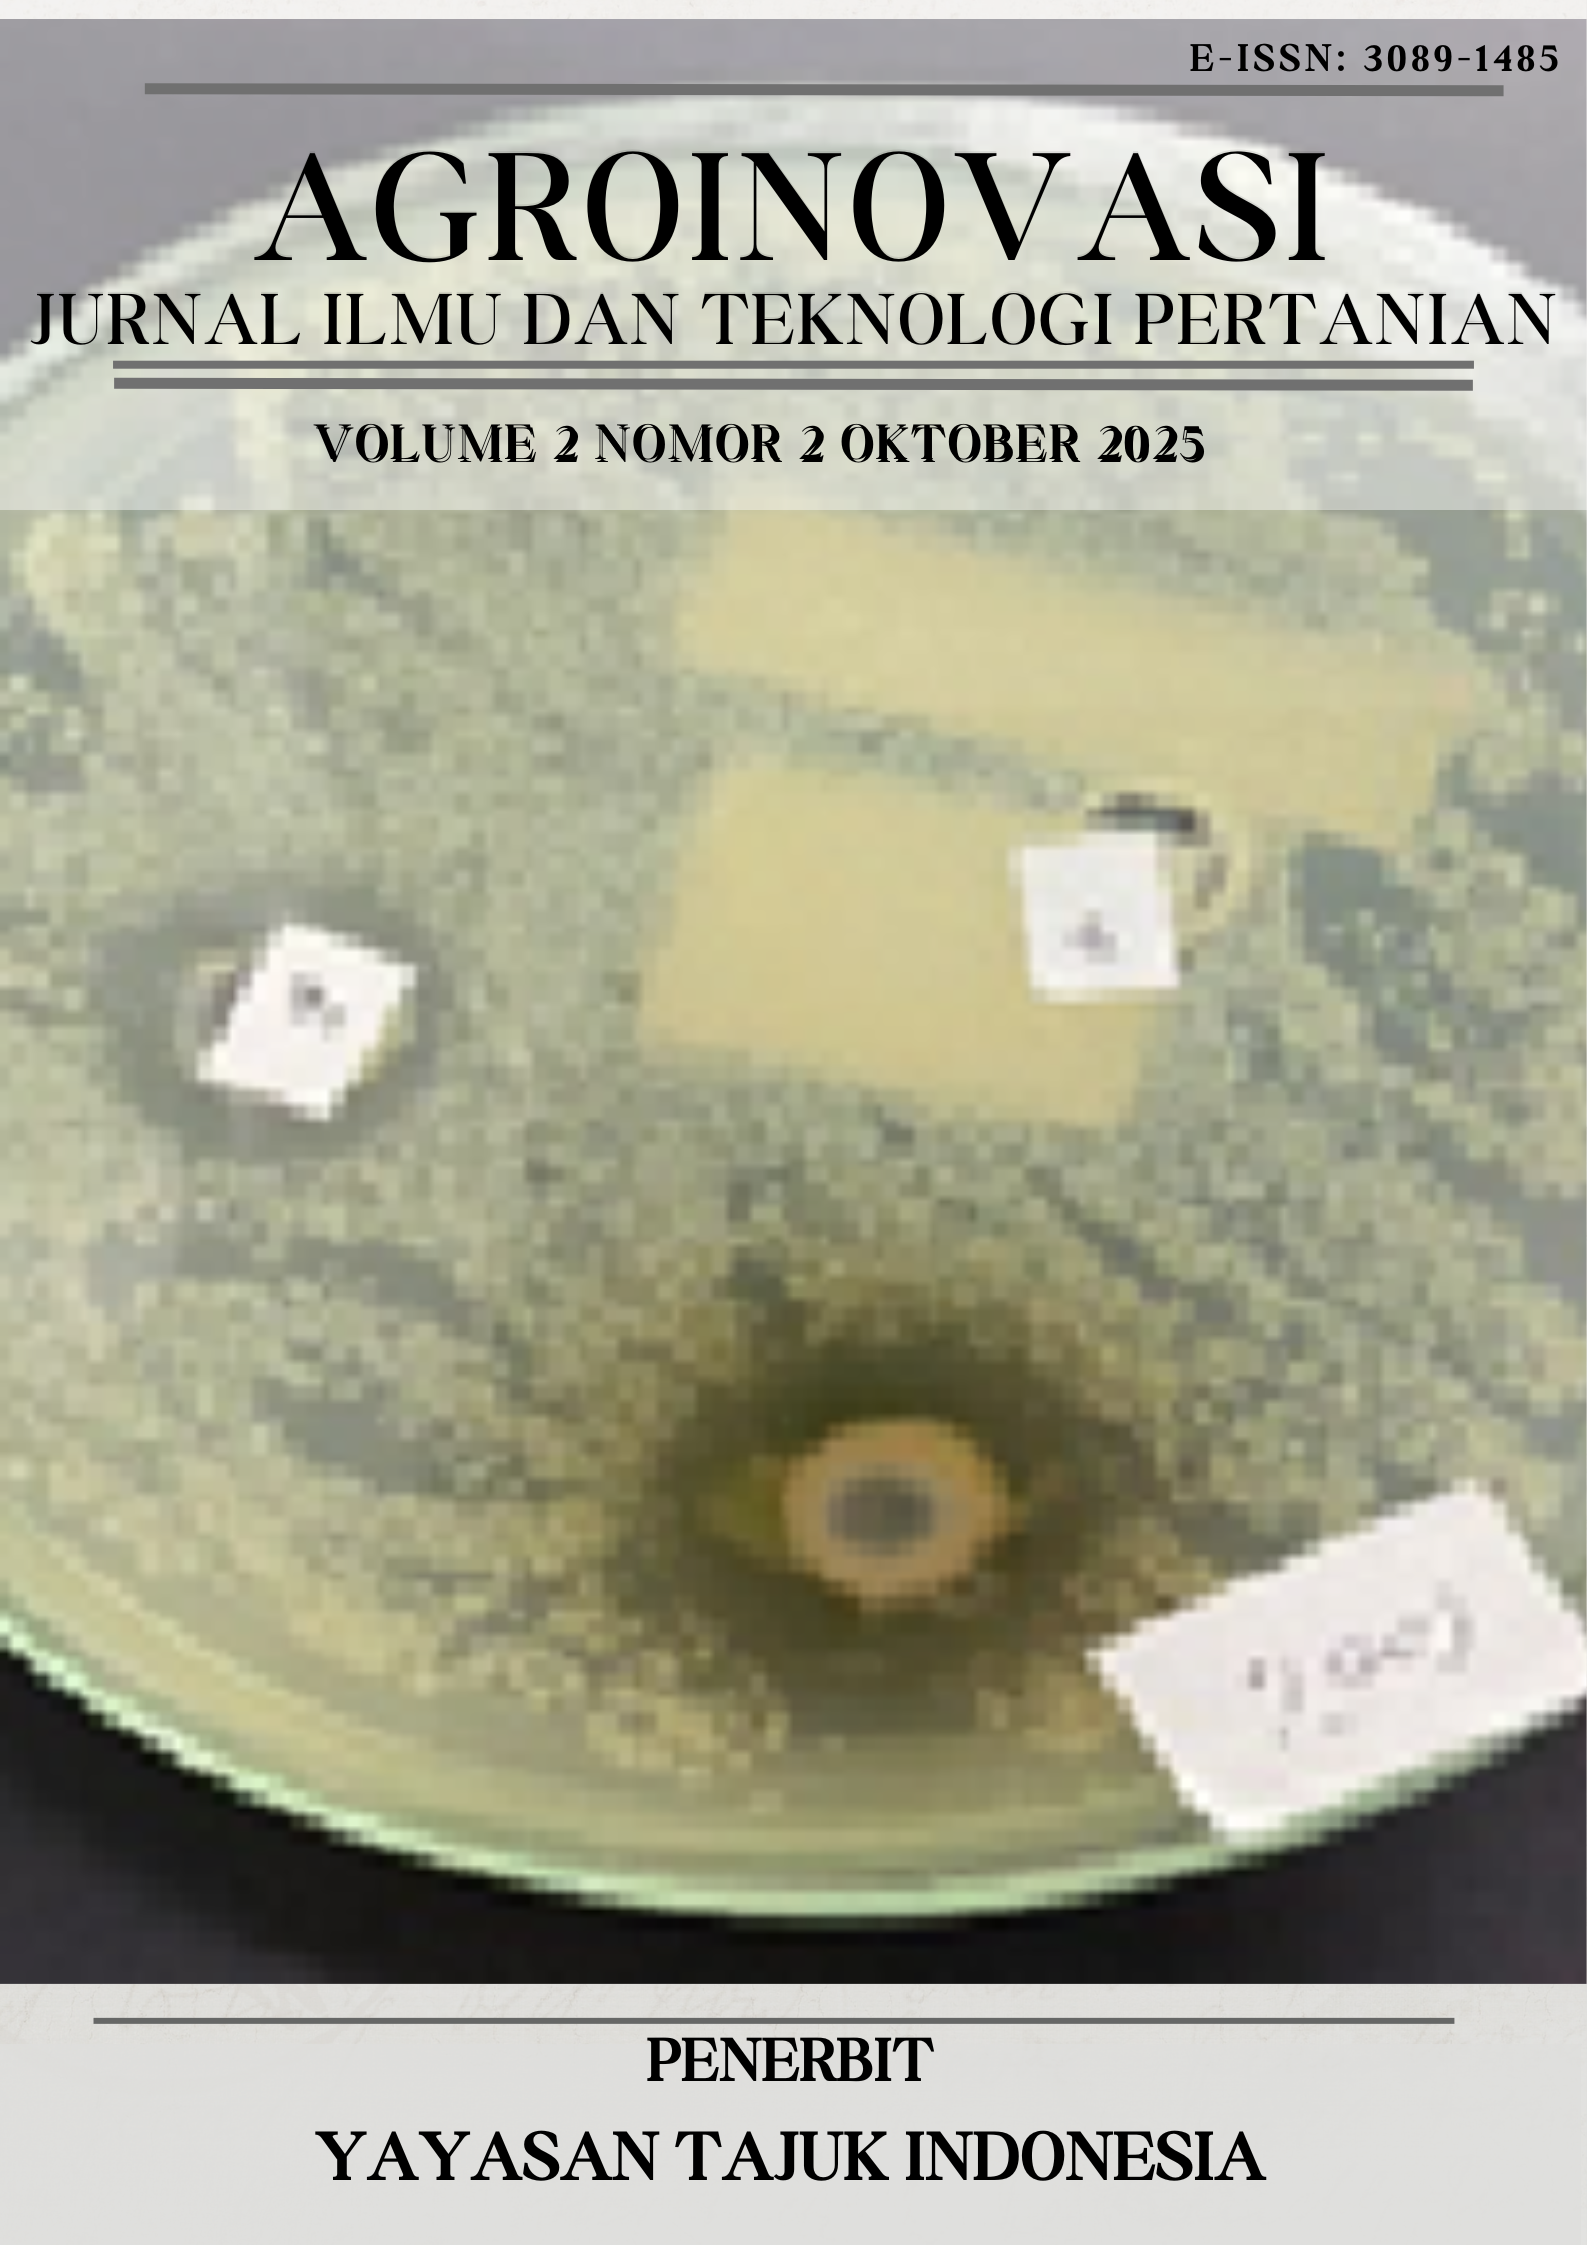
View Vol. 2 No. 2 (2025): Oktober 2025

About the Journal
Agroinovasi: Jurnal Ilmu dan Teknologi Pertanian
| Nama Jurnal | : | Agroinovasi: Jurnal Ilmu dan Teknologi Pertanian |
| ISSN elektronik | : | 3089-1485 melalui Portal ISSN |
| Awalan DOI | : | 10.71024/agroinovasi oleh Crossref |
| Frekuensi | : | April dan Oktober |
| Pemimpin redaksi | : | Dr. Alfian Pujian Hadi, SP, M.Si., M.Sc |
Agroinovasi: Jurnal Ilmu dan Teknologi Pertanian merupakan jurnal ilmiah yang fokus pada publikasi penelitian dan inovasi di bidang pertanian. Jurnal ini mencakup berbagai topik, mulai dari Pemuliaan Tanaman, Agronomi, Hortikultura, Peternakan, Teknologi pangan, Peternakan, Agroindustri, Teknologi pertanian, Pengelolaan sumber daya alam, Kehutanan, Sosial Ekonomi Kelembagaan pertanian, Pengelolaan DAS, Konservasi Tanah dan Air, Teknologi Penginderaan jauh untuk pertanian dan kehutanan. Tujuan publikasi Jurnal Agroinovasi untuk memberikan kontribusi ilmiah yang dapat mendukung kemajuan sektor pertanian melalui publikasi hasil penelitian yang relevan dan aplikatif, sehingga bermanfaat bagi peneliti, pelajar, dan praktisi.
Call for Papers Volume 3 Nomor 1, April 2026
Agroinovasi: Jurnal Ilmu dan Teknologi Pertanian diterbitkan dua kali setahun pada bulan April dan Oktober. Batas pengiriman 31 Maret 2026.
Terima kasih telah mengirimkan artikel Anda ke Agroinovasi: Jurnal Ilmu dan Teknologi Pertanian, dan kami menghargai semua dukungan Anda.
Current Issue
Volume 2 Nomor 2 Oktober 2025 terdiri atas 5 (Lima) artikel dengan sebaran jumlah penulis sebanyak 15 orang yang berasal dari perguruan tinggi dalam negeri dan luar negeri, Lembaga Penelitian meliputi: University Teknologi Mara Malaysia, IPB University, Universitas Mataram, Universitas Teknologi Submawa, dan Universitas Islam Negeri Mataram.
Cover, Sambutan Editor in Chief, dan Daftar Isi dapat didonwload disini.










